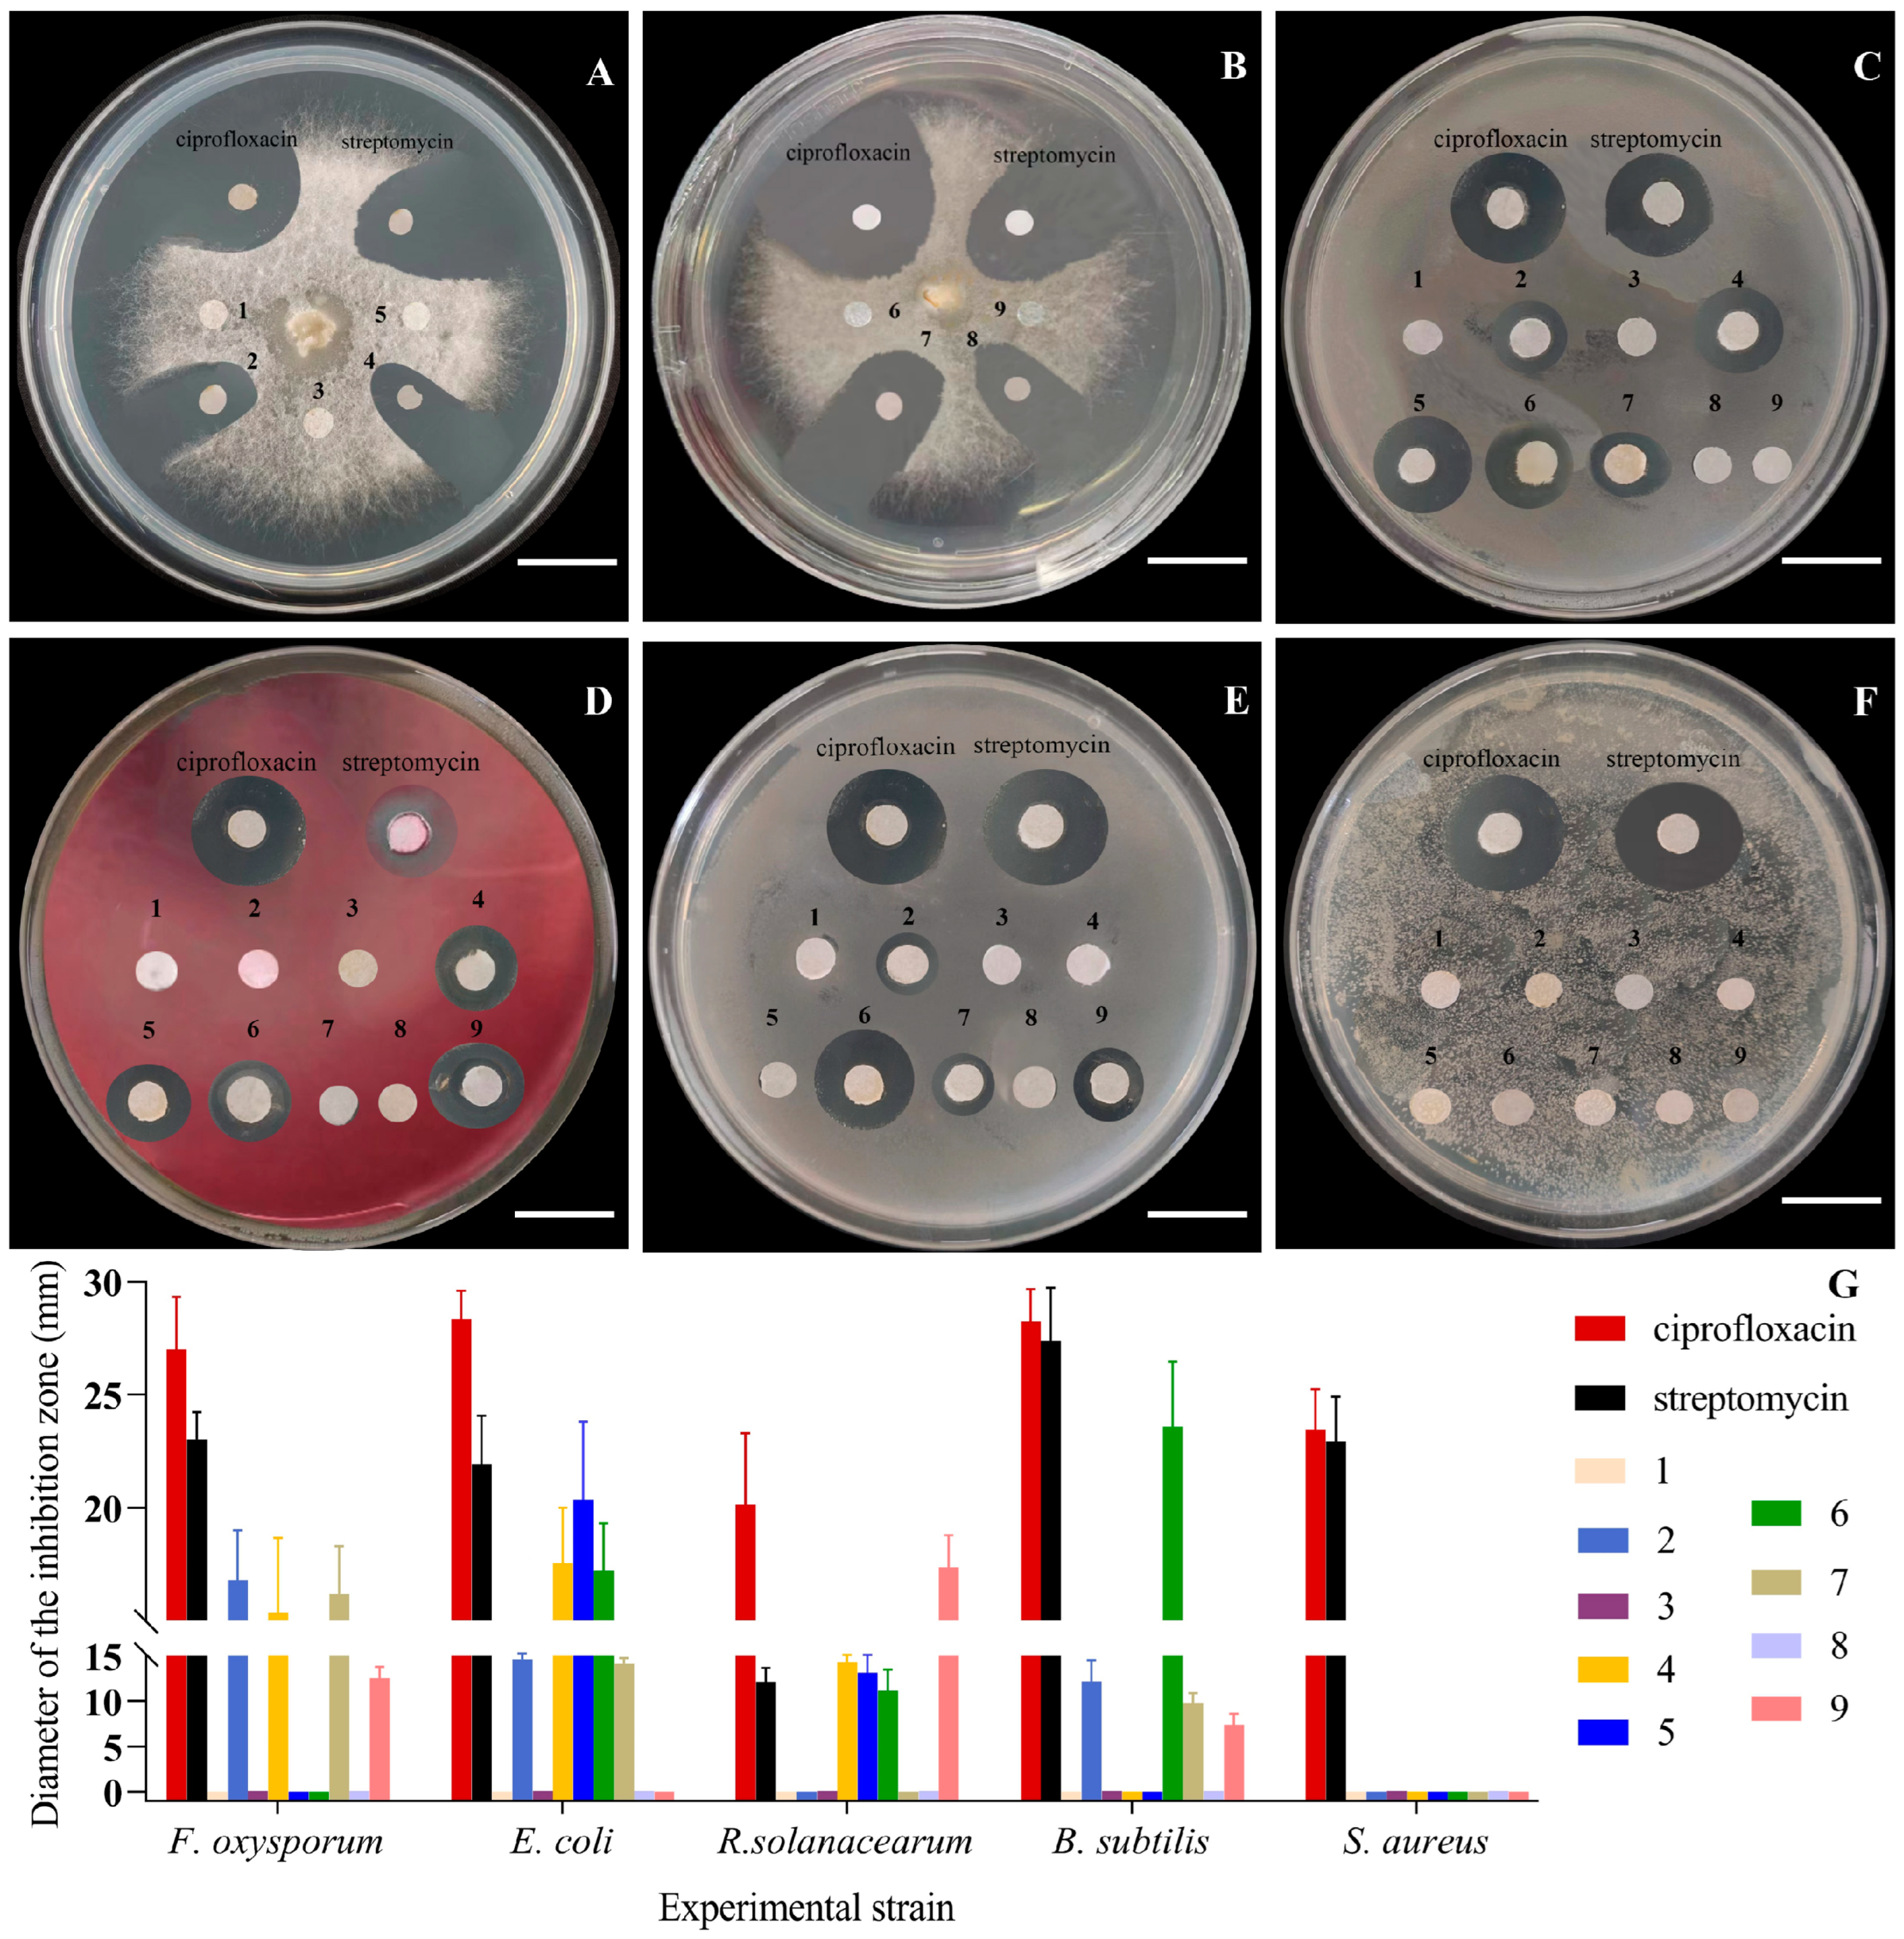
Jof 09 01175 g005

Characterization of Terpenoids from the Ambrosia Beetle Symbiont and Laurel Wilt Pathogen Harringtonia lauricola
Abstract
:1. Introduction
2. Materials and Methods
2.1. General Experimental Procedures
2.2. Identification of Fungal Species
2.3. Small-Scale Fermentation of Target Strains Based on OSMAC Strategy
2.3.1. Small-Scale Fermentation
2.3.2. HPLC Analysis
2.4. Large-Scale Fermentation
2.5. Purification of H. lauricola Metabolites
2.6. Antiproliferation Assays
2.7. Antimicrobial Activity
2.8. Antioxidant Activity
2.8.1. Determination of DPPH Radical Scavenging Activity
2.8.2. Determination of Superoxide Anion Radical (O2−) Scavenging Activity
2.9. Statistical Analyses
3. Results
3.1. Fungal Species Identification
3.1.1. Morphological Description
3.1.2. Phylogenetic Analyses
3.2. Optimization of Growth Conditions
3.3. Terpenoid Extraction
3.4. Antiproliferation Bioassays
3.5. Antimicrobial Activity
3.6. Antioxidant Activity
4. Discussion
5. Conclusions
Supplementary Materials
Author Contributions
Funding
Institutional Review Board Statement
Informed Consent Statement
Data Availability Statement
Acknowledgments
Conflicts of Interest
References
- Elramli, N.; Karahoda, B.; Sarikaya-Bayram, Ö.; Frawley, D.; Ulas, M.; Oakley, C.E.; Oakley, B.R.; Seiler, S.; Bayram, Ö. Assembly of a heptameric STRIPAK complex is required for coordination of light-dependent multicellular fungal development with secondary metabolism in Aspergillus nidulans. PLoS Genet. 2019, 15, e1008053. [Google Scholar] [CrossRef]
- Schuller, A.; Studt-Reinhold, L.; Strauss, J. How to Completely Squeeze a Fungus-Advanced Genome Mining Tools for Novel Bioactive Substances. Pharmaceutics 2022, 14, 1837. [Google Scholar] [CrossRef]
- Keshri, P.K.; Rai, N.; Verma, A.; Kamble, S.C.; Barik, S.; Mishra, P.; Singh, S.K.; Salvi, P.; Gautam, V. Biological potential of bioactive metabolites derived from fungal endophytes associated with medicinal plants. Mycol. Prog. 2021, 20, 577–594. [Google Scholar] [CrossRef]
- Robey, M.T.; Caesar, L.K.; Drott, M.T.; Keller, N.P.; Kelleher, N.L. An interpreted atlas of biosynthetic gene clusters from 1000 fungal genomes. Proc. Natl. Acad. Sci. USA 2021, 118, e2020230118. [Google Scholar] [CrossRef] [PubMed]
- Mandour, A.A.; Nabil, N.; Zaazaa, H.E.; Abdelkawy, M. Review on analytical studies of some pharmaceutical compounds containing heterocyclic rings: Brinzolamide, timolol maleate, flumethasone pivalate, and clioquinol. Future J. Pharm. Sci. 2020, 6, 52. [Google Scholar] [CrossRef]
- Cheek, M.; Nic Lughadha, E.; Kirk, P.; Lindon, H.; Carretero, J.; Looney, B.; Douglas, B.; Haelewaters, D.; Gaya, E.; Llewellyn, T.; et al. New scientific discoveries: Plants and fungi. Plants People Planet. 2020, 2, 371–388. [Google Scholar] [CrossRef]
- Newman, D.J.; Cragg, G.M. Natural Products as Sources of New Drugs over the Nearly Four Decades from 01/1981 to 09/2019. J. Nat. Prod. 2020, 83, 770–803. [Google Scholar] [CrossRef]
- Cheng, A.X.; Lou, Y.G.; Mao, Y.B.; Lu, S.; Wang, L.J.; Chen, X.Y. Plant Terpenoids: Biosynthesis and Ecological. J. Integr. Plant Biol. 2007, 49, 179–186. [Google Scholar] [CrossRef]
- Pichersky, E.; Raguso, R.A. Why do plants produce so many terpenoid compounds? New Phytol. 2018, 220, 692–702. [Google Scholar] [CrossRef]
- Guan, Y.; Chen, S.; Chen, F.; Chen, F.; Jiang, Y. Exploring the Relationship between Trichome and Terpene Chemistry in Chrysanthemum. Plants 2022, 11, 1410. [Google Scholar] [CrossRef]
- Yang, W.; Chen, X.; Li, Y.; Guo, S.; Wang, Z.; Yu, X. Advances in Pharmacological Activities of Terpenoids. Nat. Prod. Commun. 2020, 15, 1934578X20903555. [Google Scholar] [CrossRef]
- Moser, S.; Pichler, H. Identifying and engineering the ideal microbial terpenoid production host. Appl. Microbiol. Biotechnol. 2019, 103, 5501–5516. [Google Scholar] [CrossRef]
- Isah, M.B.; Tajuddeen, N.; Umar, M.I.; Alhafiz, Z.A.; Mohammed, A.; Ibrahim, M.A. Terpenoids as Emerging Therapeutic Agents: Cellular Targets and Mechanisms of Action against Protozoan Parasites. Stud. Nat. Prod. Chem. 2018, 59, 227–250. [Google Scholar] [CrossRef]
- Quin, M.B.; Flynn, C.M.; Schmidt-Dannert, C. Traversing the fungal terpenome. Nat. Prod. Rep. 2014, 31, 1449–1473. [Google Scholar] [CrossRef] [PubMed]
- Schmidt-Dannert, C. NextGen microbial natural products discovery. Microb. Biotechnol. 2015, 8, 26–28. [Google Scholar] [CrossRef] [PubMed]
- Galindo-Solis, J.M.; Fernandez, F.J. Endophytic Fungal Terpenoids: Natural Role and Bioactivities. Microorganisms 2022, 10, 339. [Google Scholar] [CrossRef]
- de Souza, J.J.; Vieira, I.J.; Rodrigues-Filho, E.; Braz-Filho, R. Terpenoids from endophytic fungi. Molecules 2011, 16, 10604–10618. [Google Scholar] [CrossRef]
- Joseph, R.; Keyhani, N.O. Fungal mutualisms and pathosystems: Life and death in the ambrosia beetle mycangia. Appl. Microbiol. Biotechnol. 2021, 105, 3393–3410. [Google Scholar] [CrossRef]
- Araujo, J.P.M.; Li, Y.; Duong, T.A.; Smith, M.E.; Adams, S.; Hulcr, J. Four New Species of Harringtonia: Unravelling the Laurel Wilt Fungal Genus. J. Fungi 2022, 8, 613. [Google Scholar] [CrossRef]
- Fraedrich, S.W. California Laurel Is Susceptible to Laurel Wilt Caused by Raffaelea lauricola. Plant Dis. 2008, 92, 1469. [Google Scholar] [CrossRef]
- Joseph, R.; Bansal, K.; Keyhani, N.O. Host switching by an ambrosia beetle fungal mutualist: Mycangial colonization of indigenous beetles by the invasive laurel wilt fungal pathogen. Environ. Microbiol. 2023, 25, 1894–1908. [Google Scholar] [CrossRef]
- Martini, X.; Hughes, M.A.; Conover, D.; Smith, J. Use of Semiochemicals for the Management of the Redbay Ambrosia Beetle. Insects 2020, 11, 796. [Google Scholar] [CrossRef]
- Zhou, Y.; Avery, P.B.; Carrillo, D.; Duncan, R.H.; Lukowsky, A.; Cave, R.D.; Keyhani, N.O. Identification of the Achilles heels of the laurel wilt pathogen and its beetle vector. Appl. Microbiol. Biotechnol. 2018, 102, 5673–5684. [Google Scholar] [CrossRef]
- Joseph, R.; Lasa, M.; Zhou, Y.; Keyhani, N.O. Unique Attributes of the Laurel Wilt Fungal Pathogen, Raffaelea lauricola, as Revealed by Metabolic Profiling. Pathogens 2021, 10, 528. [Google Scholar] [CrossRef]
- Simon, A.G.; Mills, D.K.; Furton, K.G. Chemotyping the temporal volatile organic compounds of an invasive fungus to the United States, Raffaelea lauricola. J. Chromatogr. A 2017, 1487, 72–76. [Google Scholar] [CrossRef] [PubMed]
- Zhang, Y.; Zhang, J.; Vanderpool, D.; Smith, J.A.; Rollins, J.A. Genomic and transcriptomic insights into Raffaelea lauricola pathogenesis. BMC Genom. 2020, 21, 570. [Google Scholar] [CrossRef] [PubMed]
- Ibarra Caballero, J.R.; Jeon, J.; Lee, Y.H.; Fraedrich, S.; Klopfenstein, N.B.; Kim, M.S.; Stewart, J.E. Genomic comparisons of the laurel wilt pathogen, Raffaelea lauricola, and related tree pathogens highlight an arsenal of pathogenicity related genes. Fungal Genet. Biol. 2019, 125, 84–92. [Google Scholar] [CrossRef] [PubMed]
- Liu, T.; Ren, Z.; Chunyu, W.X.; Li, G.D.; Chen, X.; Zhang, Z.T.; Sun, H.B.; Wang, M.; Xie, T.P.; Wang, M.; et al. Exploration of Diverse Secondary Metabolites from Streptomyces sp. YINM00001, Using Genome Mining and One Strain Many Compounds Approach. Front. Microbiol. 2022, 13, 831174. [Google Scholar] [CrossRef]
- Yin, M.; Duong, T.A.; Wingfield, M.J.; Zhou, X.; de Beer, Z.W. Taxonomy and phylogeny of the Leptographium procerum complex, including Leptographium sinense sp. nov. and Leptographium longiconidiophorum sp. nov. Antonie Van Leeuwenhoek 2015, 107, 547–563. [Google Scholar] [CrossRef] [PubMed]
- Stamatakis, A. RAxML version 8: A tool for phylogenetic analysis and post-analysis of large phylogenies. Bioinformatics 2014, 30, 1312–1313. [Google Scholar] [CrossRef] [PubMed]
- Qin, Y.; Zou, L.; Lei, X.; Su, J.; Yang, R.; Xie, W.; Li, W.; Chen, G. OSMAC strategy integrated with molecular networking discovery peniciacetals A-I, nine new meroterpenoids from the mangrove-derived fungus Penicillium sp. HLLG-122. Bioorg. Chem. 2022, 130, 106271. [Google Scholar] [CrossRef]
- Xie, C.L.; Liu, Q.; He, Z.H.; Gai, Y.B.; Zou, Z.B.; Shao, Z.Z.; Liu, G.M.; Chen, H.F.; Yang, X.W. Discovery of andrastones from the deep-sea-derived Penicillium allii-sativi MCCC 3A00580 by OSMAC strategy. Bioorg. Chem. 2021, 108, 104671. [Google Scholar] [CrossRef] [PubMed]
- Armin, R.; Zühlke, S.; Mahnkopp-Dirks, F.; Winkelmann, T.; Kusari, S. Evaluation of Apple Root-Associated Endophytic Streptomyces pulveraceus Strain ES16 by an OSMAC-Assisted Metabolomics Approach. Front. Sustain. Food Syst. 2021, 5, 643225. [Google Scholar] [CrossRef]
- Świecimska, M.; Golińska, P.; Goodfellow, M. Generation of a high quality library of bioactive filamentous actinomycetes from extreme biomes using a culture-based bioprospecting strategy. Front. Microbiol. 2023, 13, 1054384. [Google Scholar] [CrossRef] [PubMed]
- Wang, J.; Battini, N.; Ansari, M.F.; Zhou, C.H. Synthesis and Biological Evaluation of Quinazolonethiazoles as New Potential Conquerors towards Pseudomonas aeruginosa. Chin. J. Chem. 2021, 39, 1093–1103. [Google Scholar] [CrossRef]
- Yang, W.; Ding, H.; Qi, G.; Guo, J.; Xu, F.; Li, C.; Puglia, D.; Kenny, J.; Ma, P. Enhancing the Radical Scavenging Activity and UV Resistance of Lignin Nanoparticles via Surface Mannich Amination toward a Biobased Antioxidant. Biomacromolecules 2021, 22, 2693–2701. [Google Scholar] [CrossRef]
- Hodroj, M.H.; Jardaly, A.; Abi Raad, S.; Zouein, A.; Rizk, S. Andrographolide potentiates the antitumor effect of topotecan in acute myeloid leukemia cells through an intrinsic apoptotic pathway. Cancer Manag. Res. 2018, 10, 1079–1088. [Google Scholar] [CrossRef]
- Rubin, D.; Sansom, C.E.; Richards, D.J.; Lucas, N.T.; Garden, A.L.; Saldivia Perez, P.R.; Lord, J.M.; Perry, N.B. Halimane Diterpenes in the Alpine Daisy Celmisiaviscosa: Absolute Configuration, 2,6-Dideoxyhexopyran-3-ulosides, Conformational Flexibility, and Intraspecific Variation. J. Nat. Prod. 2022, 85, 1893–1903. [Google Scholar] [CrossRef]
- Li, W.; Zhao, L.; Sun, L.T.; Xie, Z.P.; Zhang, S.M.; Yue, X.D.; Dai, S.J. Trinorlabdane diterpenoid alkaloids featuring an un-precedented skeleton with anti-inflammatory and anti-viral activities from Forsythia suspensa. RSC Adv. 2021, 11, 29684–29689. [Google Scholar] [CrossRef]
- Xiang, K.L.; Liu, R.X.; Zhao, L.; Xie, Z.P.; Zhang, S.M.; Dai, S.J. Labdane diterpenoids from Forsythia suspensa with anti-inflammatory and anti-viral activities. Phytochemistry 2020, 173, 112298. [Google Scholar] [CrossRef]
- Kuo, P.C.; Hung, H.Y.; Nian, C.W.; Hwang, T.L.; Cheng, J.C.; Kuo, D.H.; Lee, E.J.; Tai, S.H.; Wu, T.S. Chemical Constituents and Anti-inflammatory Principles from the Fruits of Forsythia suspensa. J. Nat. Prod. 2017, 80, 1055–1064. [Google Scholar] [CrossRef] [PubMed]
- Sahu, B.; Bhardwaj, N.; Chatterjee, E.; Dey, B.; Tripathi, N.; Goel, B.; Kushwaha, M.; Kumar, B.; Singh, B.; Guru, S.K.; et al. LCMS-DNP based dereplication of Araucaria cunninghamii Mudie gum-resin: Identification of new cytotoxic labdane diterpene. Nat. Prod. Res. 2022, 36, 6207–6214. [Google Scholar] [CrossRef]
- Li, Y.L.; Zhang, Q.; Wu, J.J.; Xue, L.J.; Chen, L.M.; Tian, J.M.; Xu, Z.N.; Chen, Y.; Yang, X.W.; Hao, X.J.; et al. Nukiangendines A and B, two novel 13,14-seco-abietanes from Abies nukiangensis. Tetrahedron Lett. 2019, 60, 751–753. [Google Scholar] [CrossRef]
- Liang, Y.H.; Wang, W.; Yu, S.W.; Ye, M.; He, X.H.; Gong, N.B.; Lu, Y.; Khan, I.A.; Guo, D.A. A new chiratane type triterpenoid from the rhizomes of Drynariafortunei. Fitoterapia 2010, 81, 988–991. [Google Scholar] [CrossRef] [PubMed]
- Corbett, R.E.; Smith, R.A.J.; Young, H. Lichens and fungi. Part Vl. Dehydration rearrangements of 15-hydroxyhopanes. J. Chem. Soc. C Org. 1969, 1, 44–47. [Google Scholar] [CrossRef]
- Isaka, M.; Chinthanom, P.; Sappan, M.; Chanthaket, R.; Luangsa-ard, J.J.; Prabpai, S.; Kongsaeree, P. Lanostane and hopane triterpenes from the entomopathogenic fungus Hypocrella sp. BCC 14524. J. Nat. Prod. 2011, 74, 2143–2150. [Google Scholar] [CrossRef]
- Lasko, M.J.; Huse, H.K.; Nicolau, D.P.; Kuti, J.L. Contemporary analysis of ETEST for antibiotic susceptibility and minimum inhibitory concentration agreement against Pseudomonas aeruginosa from patients with cystic fibrosis. Ann. Clin. Microbiol. Antimicrob. 2021, 20, 9. [Google Scholar] [CrossRef]
- DiGuistini, S.; Wang, Y.; Liao, N.Y.; Taylor, G.; Tanguay, P.; Feau, N.; Henrissat, B.; Chan, S.K.; Hesse-Orce, U.; Alamouti, S.M.; et al. Genome and transcriptome analyses of the mountain pine beetle-fungal symbiont Grosmannia clavigera, a lodgepole pine pathogen. Proc. Natl. Acad. Sci. USA 2011, 108, 2504–2509. [Google Scholar] [CrossRef]
- Abbas, M.S.T. Interactions between Entomopathogenic Fungi and Entomophagous Insects. Adv. Entomol. 2020, 8, 130–146. [Google Scholar] [CrossRef]
- Ranger, C.M.; Biedermann, P.H.W.; Phuntumart, V.; Beligala, G.U.; Ghosh, S.; Palmquist, D.E.; Mueller, R.; Barnett, J.; Schultz, P.B.; Reding, M.E.; et al. Symbiont selection via alcohol benefits fungus farming by ambrosia beetles. Proc. Natl. Acad. Sci. USA 2018, 115, 4447–4452. [Google Scholar] [CrossRef]
- Yao, Y.; Pan, S.; Wang, K.; Xu, X. Fermentation process improvement of a Chinese traditional food: Soybean residue cake. J. Food Sci. 2010, 75, M417–M421. [Google Scholar] [CrossRef] [PubMed]
- Nwaefuna, A.E.; Rumbold, K.; Boekhout, T.; Zhou, N. Bioethanolic yeasts from dung beetles: Tapping the potential of ex-tremophilic yeasts for improvement of lignocellulolytic feedstock fermentation. Biotechnol. Biofuels 2021, 14, 86. [Google Scholar] [CrossRef] [PubMed]
- Gavahian, M.; Mathad, G.N.; Oliveira, C.A.F.; Mousavi Khaneghah, A. Combinations of emerging technologies with fermen-tation: Interaction effects for detoxification of mycotoxins? Food Res. Int. 2021, 141, 110104. [Google Scholar] [CrossRef] [PubMed]
- Wang, F.; Cale, J.A.; Hussain, A.; Erbilgin, N. Exposure to Fungal Volatiles Can Influence Volatile Emissions From Other Ophiostomatoid Fungi. Front. Microbiol. 2020, 11, 567462. [Google Scholar] [CrossRef] [PubMed]
- Cale, J.A.; Collignon, R.M.; Klutsch, J.G.; Kanekar, S.S.; Hussain, A.; Erbilgin, N. Fungal Volatiles Can Act as Carbon Sources and Semiochemicals to Mediate Interspecific Interactions among Bark Beetle-Associated Fungal Symbionts. PLoS ONE 2016, 11, e0162197. [Google Scholar] [CrossRef] [PubMed]
- Cale, J.A.; Ding, R.; Wang, F.; Rajabzadeh, R.; Erbilgin, N. Ophiostomatoid fungi can emit the bark beetle pheromone verbenone and other semiochemicals in media amended with various pine chemicals and beetle-released compounds. Fungal Ecol. 2019, 39, 285–295. [Google Scholar] [CrossRef]
- Shibata, H.; Irie, A.; Morita, Y. New Antibacterial Diterpenoids from the Sarcodon scabrosus Fungus. Biosci. Biotechnol. Biochem. 1998, 62, 2450–2452. [Google Scholar] [CrossRef]
- Xiong, Z.J.; Huang, J.; Yan, Y.; Wang, L.; Wang, Z.; Yang, J.; Luo, J.; Li, J.; Huang, S.X. Isolation and biosynthesis of labdanmy-cins: Four new labdane diterpenes from endophytic Streptomyces. Org. Chem. Front. 2018, 5, 1272–1279. [Google Scholar] [CrossRef]
- Choudhary, M.; Kumar, V.; Naik, B.; Verma, A.; Saris, P.E.J.; Kumar, V.; Gupta, S. Antifungal metabolites, their novel sources, and targets to combat drug resistance. Front. Microbiol. 2022, 13, 1061603. [Google Scholar] [CrossRef]
- Zhang, Y.; Li, T.; Xu, M.; Guo, J.; Zhang, C.; Feng, Z.; Peng, X.; Li, Z.; Xing, K.; Qin, S. Antifungal effect of volatile organic compounds produced by Pseudomonas chlororaphis subsp. aureofaciens SPS-41 on oxidative stress and mitochondrial dys-function of Ceratocystis fimbriata. Pestic. Biochem. Physiol. 2021, 173, 104777. [Google Scholar] [CrossRef]
- Saritha, K.; Rajesh, A.; Manjulatha, K.; Setty, O.H.; Yenugu, S. Mechanism of antibacterial action of the alcoholic extracts of Hemidesmus indicus (L.) R. Br. ex Schult, Leucas aspera (Wild.), Plumbago zeylanica L., and Tridax procumbens (L.) R. Br. ex Schult. Front. Microbiol. 2015, 6, 577. [Google Scholar] [CrossRef] [PubMed]
- Sitarek, P.; Synowiec, E.; Kowalczyk, T.; Bangay, G.; Sliwinski, T.; Picot, L.; Princiotto, S.; Rijo, P. Anticancer Properties of Plectranthus ornatus-Derived Phytochemicals Inducing Apoptosis via Mitochondrial Pathway. Int. J. Mol. Sci. 2022, 23, 11653. [Google Scholar] [CrossRef] [PubMed]
- Acquaviva, R.; Malfa, G.A.; Loizzo, M.R.; Xiao, J.; Bianchi, S.; Tundis, R. Advances on Natural Abietane, Labdane and Cler-odane Diterpenes as Anti-Cancer Agents: Sources and Mechanisms of Action. Molecules 2022, 27, 4791. [Google Scholar] [CrossRef] [PubMed]
- Khan, I.; Khan, F.; Farooqui, A.; Ansari, I.A. Andrographolide Exhibits Anticancer Potential Against Human Colon Cancer Cells by Inducing Cell Cycle Arrest and Programmed Cell Death via Augmentation of Intracellular Reactive Oxygen Species Level. Nutr. Cancer 2018, 70, 787–803. [Google Scholar] [CrossRef]
- Gong, G.; Shen, Y.L.; Lan, H.Y.; Jin, J.M.; An, P.; Zhang, L.J.; Chen, L.L.; Peng, W.; Luan, X.; Zhang, H. The Cyr61 Is a Potential Target for Rotundifuran, a Natural Labdane-Type Diterpene from Vitex trifolia L., to Trigger Apoptosis of Cervical Cancer Cells. Oxid. Med. Cell. Longev. 2021, 2021, 6677687. [Google Scholar] [CrossRef] [PubMed]
- Ren, Y.; Kinghorn, A.D. Development of Potential Antitumor Agents from the Scaffolds of Plant-Derived Terpenoid Lactones. J. Med. Chem. 2020, 63, 15410–15448. [Google Scholar] [CrossRef]
- Ilyasov, I.R.; Beloborodov, V.L.; Selivanova, I.A.; Terekhov, R.P. ABTS/PP Decolorization Assay of Antioxidant Capacity Reaction Pathways. Int. J. Mol. Sci. 2020, 21, 1131. [Google Scholar] [CrossRef]
- He, Y.; Bu, L.; Xie, H.; Liang, G. Antioxidant activities and protective effects of duck embryo peptides against H2O2-induced oxidative damage in HepG2 cells. Poult. Sci. 2019, 98, 7118–7128. [Google Scholar] [CrossRef]
- Naka, K.; Muraguchi, T.; Hoshii, T.; Hirao, A. Regulation of reactive oxygen species and genomic stability in hematopoietic stem cells. Antioxid. Redox Signal. 2008, 10, 1883–1894. [Google Scholar] [CrossRef]
- Tan, L.H.; Zhang, D.; Yu, B.; Zhao, S.P.; Wang, J.W.; Yao, L.; Cao, W.G. Antioxidant activity and optimization of extraction of polysaccharide from the roots of Dipsacus asperoides. Int. J. Biol. Macromol. 2015, 81, 332–339. [Google Scholar] [CrossRef] [PubMed]
- Wu, J.; Sun, B.; Luo, X.; Zhao, M.; Zheng, F.; Sun, J.; Li, H.; Sun, X.; Huang, M. Cytoprotective effects of a tripeptide from Chinese Baijiu against AAPH-induced oxidative stress in HepG2 cells via Nrf2 signaling. RSC Adv. 2018, 8, 10898–10906. [Google Scholar] [CrossRef] [PubMed]
- Tao, L.; Gu, F.; Liu, Y.; Yang, M.; Wu, X.Z.; Sheng, J.; Tian, Y. Preparation of antioxidant peptides from Moringa oleifera leaves and their protection against oxidative damage in HepG2 cells. Front. Nutr. 2022, 9, 1062671. [Google Scholar] [CrossRef] [PubMed]

| Compounds | In Vitro Antiproliferative IC50 (μM) | ||
|---|---|---|---|
| MCF-7 (Breast) | HepG2 (Liver) | A549 (Lung) | |
| 1 | - | - | - |
| 2 | 23.16 ± 0.96 | 16.90 ± 0.68 | 19.88 ± 1.02 |
| 3 | - | - | - |
| 4 | 26.06 ± 0.63 | 15.42 ± 0.52 | 18.43 ± 0.74 |
| 5 | 21.48 ± 0.31 | 12.54 ± 0.33 | 15.11 ± 0.41 |
| 6 | 27.31 ± 0.59 | 38.46 ± 0.38 | 27.53 ± 0.45 |
| 7 | 48.61 ± 0.22 | 53.65 ± 0.34 | 36.52 ± 0.12 |
| 8 | - | - | - |
| 9 | - | 18.81 ± 1.25 | - |
| cisplatin | 3.10 ± 0.57 | 2.40 ± 0.42 | 1.50 ± 0.81 |
| Compounds | Minimal Inhibitory Concentration (MIC, μg/mL) | ||||
|---|---|---|---|---|---|
| F. oxysporum | E. coli | R. solanacearum | B. subtilis | S. aureus | |
| 1 | - | - | - | - | - |
| 2 | 6.25 | 12.50 | - | 50.00 | - |
| 3 | - | - | - | - | - |
| 4 | 12.50 | 6.25 | 12.50 | - | - |
| 5 | - | 3.13 | 12.50 | - | - |
| 6 | - | 6.25 | 25.00 | 3.13 | - |
| 7 | 6.25 | 12.5 | - | 50.00 | - |
| 8 | - | - | - | - | - |
| 9 | 25.00 | - | 6.25 | 25.00 | - |
| ciprofloxacin | 0.78 | 0.78 | 3.13 | 0.78 | 1.56 |
| streptomycin | 1.56 | 3.13 | 12.50 | 0.78 | 1.56 |
| Compounds | IC50 (μg/mL) | |
|---|---|---|
| DPPH Radical Scavenging | Superoxide Radical Scavenging | |
| 1 | - | - |
| 2 | 3.45 ± 1.41 | 25.38 ± 1.44 |
| 3 | >50.00 | >50.00 |
| 4 | 14.04 ± 1.42 | 43.31 ± 1.46 |
| 5 | - | - |
| 6 | 12.37 ± 1.27 | 22.87 ± 1.35 |
| 7 | - | >50.00 |
| 8 | - | - |
| 9 | - | - |
| BHT | 6.42 ± 1.93 | 14.43 ± 0.38 |
| VC | 1.70 ± 1.11 | 8.518 ± 0.57 |
Disclaimer/Publisher’s Note: The statements, opinions and data contained in all publications are solely those of the individual author(s) and contributor(s) and not of MDPI and/or the editor(s). MDPI and/or the editor(s) disclaim responsibility for any injury to people or property resulting from any ideas, methods, instructions or products referred to in the content. |
© 2023 by the authors. Licensee MDPI, Basel, Switzerland. This article is an open access article distributed under the terms and conditions of the Creative Commons Attribution (CC BY) license (https://creativecommons.org/licenses/by/4.0/).
Share and Cite
Zhu, Z.; Yang, C.; Keyhani, N.O.; Liu, S.; Pu, H.; Jia, P.; Wu, D.; Stevenson, P.C.; Fernández-Grandon, G.M.; Pan, J.; et al. Characterization of Terpenoids from the Ambrosia Beetle Symbiont and Laurel Wilt Pathogen Harringtonia lauricola. J. Fungi 2023, 9, 1175. https://doi.org/10.3390/jof9121175
Zhu Z, Yang C, Keyhani NO, Liu S, Pu H, Jia P, Wu D, Stevenson PC, Fernández-Grandon GM, Pan J, et al. Characterization of Terpenoids from the Ambrosia Beetle Symbiont and Laurel Wilt Pathogen Harringtonia lauricola. Journal of Fungi. 2023; 9(12):1175. https://doi.org/10.3390/jof9121175
Chicago/Turabian StyleZhu, Zhiqiang, Chenjie Yang, Nemat O. Keyhani, Sen Liu, Huili Pu, Peisong Jia, Dongmei Wu, Philip C. Stevenson, G. Mandela Fernández-Grandon, Jieming Pan, and et al. 2023. "Characterization of Terpenoids from the Ambrosia Beetle Symbiont and Laurel Wilt Pathogen Harringtonia lauricola" Journal of Fungi 9, no. 12: 1175. https://doi.org/10.3390/jof9121175
APA StyleZhu, Z., Yang, C., Keyhani, N. O., Liu, S., Pu, H., Jia, P., Wu, D., Stevenson, P. C., Fernández-Grandon, G. M., Pan, J., Chen, Y., Guan, X., & Qiu, J. (2023). Characterization of Terpenoids from the Ambrosia Beetle Symbiont and Laurel Wilt Pathogen Harringtonia lauricola. Journal of Fungi, 9(12), 1175. https://doi.org/10.3390/jof9121175

